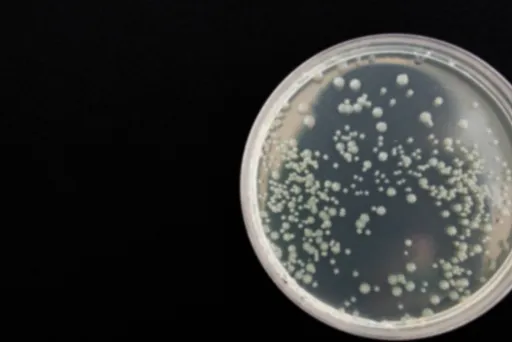

성인들 사이에서 가장 널리 알려진 성병 중 하나인 헤르페스 2형(Herpes Simplex Virus 2, HSV-2)에 대해 자세히 알아보겠습니다. 이 질병은 성적 접촉을 통해 전염되며, 평생 체내에 존재하게 되는 특징이 있죠. 그렇다면 헤르페스 2형의 정의, 증상, 예방법, 치료법 등 알아야 할 모든 것을 종합적으로 살펴보겠습니다.
헤르페스 2형이란?
헤르페스 2형은 주로 성적 접촉을 통해 전파되는 바이러스 감염 질환입니다. 이 바이러스는 피부와 점막에 감염되어 물집을 형성하게 되죠. 한 번 감염되면 평생 체내에 잠복하며, 면역력 저하 시 반복적으로 재발할 수 있습니다. 따라서 이 질병에 대한 올바른 이해와 관리가 매우 중요합니다.
헤르페스 2형의 주요 증상
헤르페스 2형의 대표적인 증상은 다음과 같습니다.
물집 및 궤양 형성
감염 초기에는 작고 투명한 물집이 생기며, 이 물집이 터지면 붉은 색의 궤양이 생깁니다. 물집이 생기는 부위는 심한 통증과 가려움증을 동반합니다.
전신 증상
감염 초기에는 발열, 두통, 근육통 등의 전신 증상이 나타날 수 있습니다. 이는 면역 체계의 반응으로 볼 수 있죠.
증상의 다양성
헤르페스 2형은 증상이 전혀 없는 경우부터 심각한 통증과 불편함을 동반하는 경우까지 개인차가 큽니다. 따라서 지속적으로 관찰하며 변화를 주시해야 합니다.
헤르페스 2형의 재발 원인
헤르페스 2형은 한 번 감염되면 완치가 어려우며, 면역력 저하 시 반복적으로 재발할 수 있습니다. 주요 재발 요인은 다음과 같습니다.
스트레스
과도한 스트레스는 면역력을 떨어뜨려 재발을 유발할 수 있습니다.
피로
충분한 휴식을 취하지 않으면 면역력이 저하되어 재발 위험이 높아집니다.
면역력 저하
만성 질환, 나이 듦 등으로 인한 면역력 저하가 재발의 주요 원인이 될 수 있습니다.
헤르페스 2형의 예방 및 관리
헤르페스 2형에 대한 효과적인 예방과 관리를 위해서는 다음과 같은 방법을 고려해볼 수 있습니다:
안전한 성관계
콘돔 사용, 감염자와의 접촉 회피 등 안전한 관계를 갖는 것이이 중요합니다.
면역력 관리
균형 잡힌 식단, 규칙적인 운동, 충분한 수면 등으로 면역력을 높이는 것이 도움이 됩니다.
전문의 상담 및 치료
증상이 나타나면 즉시 피부과나 감염내과 전문의와 상담하여 적절한 치료를 받아야 합니다. 헤르페스 2형은 성병의 대표적인 사례로, 한 번 감염되면 평생 관리해야 하는 질병입니다. 하지만 예방과 관리에 힘쓴다면 건강한 삶을 누릴 수 있습니다.
증상이 나타나면 빠른 조치가 중요하며, 평소 면역력 관리에도 힘써주세요.여러분의 건강을 위해 이렇게 정보를 제공해 드립니다. 감사합니다.

댓글